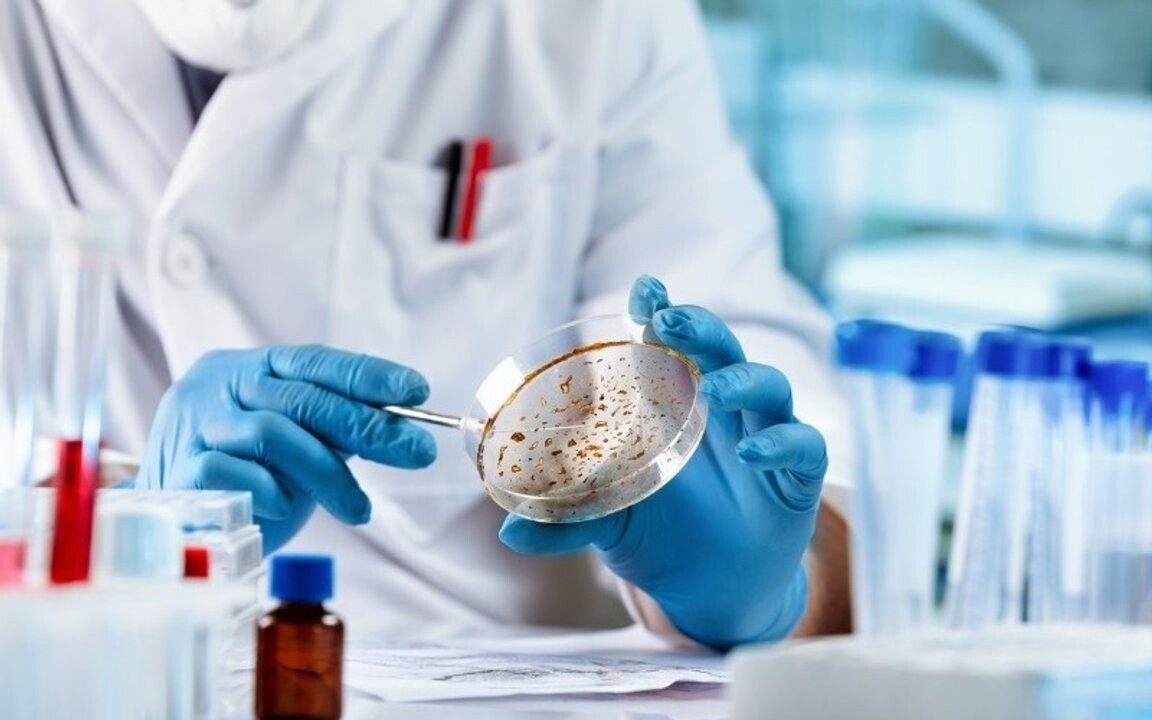
Australian Scientists Create Catalog for Pediatric Cancer Treatment

Australian scientists have developed a pioneering catalog of pediatric cancers that offers new and crucial perspectives for the advancement of immunotherapy, specifically designed for young patients. The resource, named the Childhood Cancer Model Atlas (CCMA) and based at the Hudson Institute of Medical Research, houses the world's largest collection of over 400 high-risk pediatric cancer cell lines, according to the Argentine News Agency. The institute states that this database is designed for testing and analyzing treatments driven by Artificial Intelligence (AI). The creation of this catalog represents an effort to accelerate the discovery of biomarkers and new therapies for childhood cancers. Pediatric cancers are a leading cause of disease-related death in children and often respond poorly to immunotherapies designed for adults.
Claire Xin Sun, lead author of the study from the Hudson Institute and Monash University, explained the importance of these findings: "HLA are proteins on the surface of cells that the immune system uses to distinguish between 'self' and 'non-self'. We analyzed more than 200 cell lines from the CCMA collection to identify two crucial characteristics for the immune system: the type of HLA (Human Leukocyte Antigens) and the potential neoantigens that each cell line presents to the immune system."
Knowing the type of HLA is fundamental, as it helps determine which neoantigens can be effectively recognized by the immune system. The study, published in the journal iScience, will help researchers identify which tumors have processable antigens, making them ideal candidates for immunotherapy. Furthermore, current therapies can cause long-lasting side effects in the growing bodies of children.
The key to neoantigens
Neoantigens are small abnormal protein pieces that form when cancer cells mutate. Using this information, we predicted which neoantigens each cancer model could produce and present. The ultimate goal is to guide the development of safer and more effective immunotherapies.














